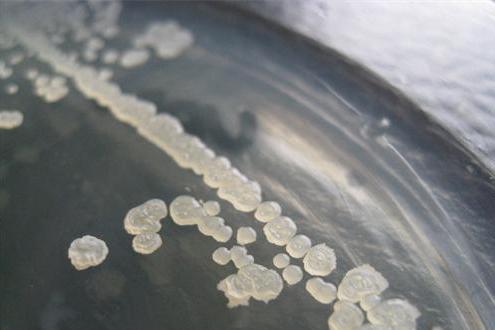
芽孢(endospore)又称 a href="#" data-lemmaid="7279164">内生孢子

芽生孢子
![[分享] 芽孢图片](https://imgs.wantubizhi.com/img/A1A61BAA66193547F3A6DD7D8EE527E9C9565FBF8BD8E398DB6CA7418FC38D0BDE715A7F44335CDAF73903B8587929CB00CBFC53C29D2689468433C04F292E5847DF747061F8CD6BC49631FA30772DF8462A136CE80852CE554B0B9588A29BB1)
[分享] 芽孢图片
图片尺寸3264x1836
芽孢(endospore)又称 a href="#" data-lemmaid="7279164">内生孢子
图片尺寸1306x879
什么是芽孢
图片尺寸900x697
细菌的芽孢
图片尺寸464x567
下面这张图片是芽孢吗
图片尺寸800x602
生长速度如何?我感觉像是木霉.
图片尺寸400x447
蜡状芽孢杆菌的介绍
图片尺寸3264x2448
原装优质芽籽孢子甘蓝种子抱子甘蓝种子迷你小甘蓝籽包菜蔬菜种子
图片尺寸800x800
请问各位大佬图片中有几种芽孢形态
图片尺寸4032x3024
论坛
图片尺寸2272x1704
芽孢(endospore)又称 a href="#" data-lemmaid="7279164">内生孢子
图片尺寸800x600
什么是芽孢
图片尺寸500x354
细菌芽孢在光学显微镜 下的形态及其在胞内的 位置
图片尺寸1080x810
请问各位大佬图片中有几种芽孢形态
图片尺寸4032x3024
p> a href="#" data-lemmaid="9492941">芽孢杆菌属 /a>( i>bacillus
图片尺寸1200x794
芽孢杆菌
图片尺寸754x1008
来之不易的照片
图片尺寸1728x2304
图② 芽孢在芽孢囊中的形态和着生位置
图片尺寸799x299
孢子芽图片
图片尺寸451x300
芽孢(endospore)又称 a href="#" data-lemmaid="7279164">内生孢子
图片尺寸495x330
![[分享] 芽孢图片](https://imgs.wantubizhi.com/img/A1A61BAA66193547F3A6DD7D8EE527E9C9565FBF8BD8E398DB6CA7418FC38D0BDE715A7F44335CDAF73903B8587929CB00CBFC53C29D2689468433C04F292E5847DF747061F8CD6BC49631FA30772DF8462A136CE80852CE554B0B9588A29BB1)














![[分享] 芽孢图片](https://file3.foodmate.net/attachment/forum/201212/21/164745er8jjmnmj8x8jzjr.jpg)